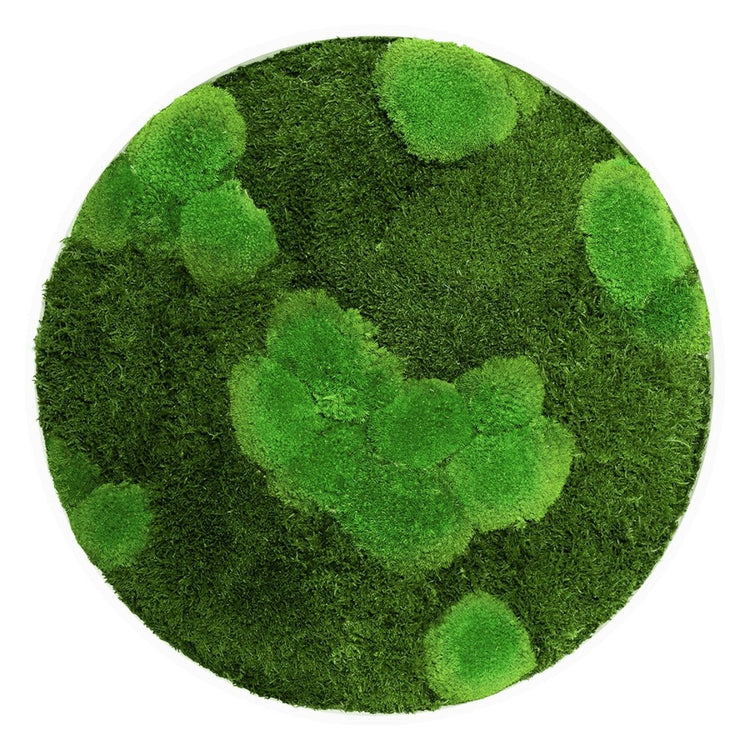

Dream in Green
Moosbild Mix-Moos 80 cm RUND
- Normaler Preis
- 519,00 €
- Verkaufspreis
- 519,00 €
- Normaler Preis
-
Anzahl
Lieferzeit: ca. 10-14 Arbeitstage
Beschreibung
Lassen Sie sich verzaubern von der natürlichen Schönheit und Harmonie unserer Mix-Moosbilder. Ein Meisterwerk, das die eleganten Strukturen des Plattenmooses (70%) mit der erhabenen Textur des Hügelmooses (30%) vereint. Die harmonische Zusammensetzung macht jedes Moosbild zu einem echten Blickfang, das Ihre Räume in ein grünes Wunderland verwandelt.
Jedes unserer Moosbilder spiegelt unsere Leidenschaft für höchste Qualität wider. Wir setzen ausschließlich auf konserviertes Moos in Premium Qualität. Was bedeutet das für Sie? Eine beeindruckende Langlebigkeit und absolute Pflegefreiheit. Kein Gießen, kein Beschneiden – einfach genießen.
Ihre Vorteile im Überblick:
- Premium Qualität: 100% konserviertes Moos garantiert jahrelange Frische und intensive Farbbrillanz
- Pflegefrei: Dank der Konservierung bleibt das Moos jahrelang schön ohne jegliche Pflege
- Handgefertigte Rahmen: Unsere Rahmen werden von lokalen Schreinern speziell für unsere Moosbilder handgefertigt und veredelt
- Umweltfreundliche Verarbeitung: Die Rahmen erhalten eine Spritzlackierung auf Wasserbasis in den Farben Weiß oder Schwarz – ökologisch und stilvoll zugleich
- Komplettpaket: Mit vormontierter Aufhängung sowie Schrauben und Universal Dübeln für eine einfache und schnelle Montage (Hinweis: Bitte prüfen Sie die Wandbeschaffenheit vor Ort, gegebenenfalls müssen passende Schrauben und Dübel separat erworben werden)
Schmücken Sie Ihre Wände mit einem Kunstwerk, das die Ruhe und Ästhetik der Natur in Ihre Räume bringt. Bestellen Sie jetzt unser Mix-Moos Bild und erleben Sie die Faszination von echtem Moos, kombiniert mit traditionellem Handwerk.
Hinweise
Bitte beachten Sie unsere Hinweise
- Nicht mit Wasser befeuchten oder gießen.
- Vermeiden Sie langanhaltende Sonnen- oder Lichteinwirkung.
- Platzieren Sie das Produkt nicht in der Nähe von Hitzequellen wie Kaminen oder Heizungen.
- Vermeiden Sie extrem hohe Luftfeuchtigkeit von über 70% sowie zu trockene Luft.
- Berührung mit dem Moos kann zu Farbabgabe führen.
- Bitte beachten Sie, dass unsere Pflanzen und Moose vollständig natürliche Erzeugnisse sind. Daher können gelegentliche Veränderungen auftreten, einschließlich Farbveränderungen.
- Das Moos kann anfänglich seinen natürlichen Duft ausströmen, was jedoch gesundheitlich unbedenklich ist und innerhalb von etwa 3-5 Wochen verfliegt.
- Aufgrund der natürlichen Beschaffenheit unseres Mooses kann die Form und Farbe von den Abbildungen abweichen.
Beschreibung
Lassen Sie sich verzaubern von der natürlichen Schönheit und Harmonie unserer Mix-Moosbilder. Ein Meisterwerk, das die eleganten Strukturen des Plattenmooses (70%) mit der erhabenen Textur des Hügelmooses (30%) vereint. Die harmonische Zusammensetzung macht jedes Moosbild zu einem echten Blickfang, das Ihre Räume in ein grünes Wunderland verwandelt.
Jedes unserer Moosbilder spiegelt unsere Leidenschaft für höchste Qualität wider. Wir setzen ausschließlich auf konserviertes Moos in Premium Qualität. Was bedeutet das für Sie? Eine beeindruckende Langlebigkeit und absolute Pflegefreiheit. Kein Gießen, kein Beschneiden – einfach genießen.
Ihre Vorteile im Überblick:
- Premium Qualität: 100% konserviertes Moos garantiert jahrelange Frische und intensive Farbbrillanz
- Pflegefrei: Dank der Konservierung bleibt das Moos jahrelang schön ohne jegliche Pflege
- Handgefertigte Rahmen: Unsere Rahmen werden von lokalen Schreinern speziell für unsere Moosbilder handgefertigt und veredelt
- Umweltfreundliche Verarbeitung: Die Rahmen erhalten eine Spritzlackierung auf Wasserbasis in den Farben Weiß oder Schwarz – ökologisch und stilvoll zugleich
- Komplettpaket: Mit vormontierter Aufhängung sowie Schrauben und Universal Dübeln für eine einfache und schnelle Montage (Hinweis: Bitte prüfen Sie die Wandbeschaffenheit vor Ort, gegebenenfalls müssen passende Schrauben und Dübel separat erworben werden)
Schmücken Sie Ihre Wände mit einem Kunstwerk, das die Ruhe und Ästhetik der Natur in Ihre Räume bringt. Bestellen Sie jetzt unser Mix-Moos Bild und erleben Sie die Faszination von echtem Moos, kombiniert mit traditionellem Handwerk.
Hinweise
Bitte beachten Sie unsere Hinweise
- Nicht mit Wasser befeuchten oder gießen.
- Vermeiden Sie langanhaltende Sonnen- oder Lichteinwirkung.
- Platzieren Sie das Produkt nicht in der Nähe von Hitzequellen wie Kaminen oder Heizungen.
- Vermeiden Sie extrem hohe Luftfeuchtigkeit von über 70% sowie zu trockene Luft.
- Berührung mit dem Moos kann zu Farbabgabe führen.
- Bitte beachten Sie, dass unsere Pflanzen und Moose vollständig natürliche Erzeugnisse sind. Daher können gelegentliche Veränderungen auftreten, einschließlich Farbveränderungen.
- Das Moos kann anfänglich seinen natürlichen Duft ausströmen, was jedoch gesundheitlich unbedenklich ist und innerhalb von etwa 3-5 Wochen verfliegt.
- Aufgrund der natürlichen Beschaffenheit unseres Mooses kann die Form und Farbe von den Abbildungen abweichen.
Produktinformation